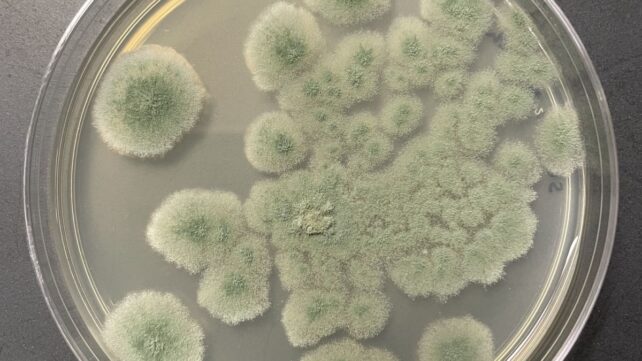
This Fungus Can Survive Deep-Space Conditions &ndash; And Could Hitch a Ride to Mars

The next mission to Mars could carry along some uninvited guests.
According to a new study of organisms found living in NASA cleanrooms even after decontamination, a fungus called Aspergillus calidoustus could very well be hardy enough to survive the radiation, near-vacuum, and temperature conditions of deep space.
"This does not mean contamination of Mars is likely, but it helps us better quantify potential microbial survival risks," says microbiologist Kasthuri Venkateswaran of NASA's Jet Propulsion Laboratory. "Microorganisms can possess extraordinary resilience to environmental stresses."
When we send probes to explore the Solar System, they can carry unintended lifeforms with them.
Although decontamination procedures minimize the number of microbial spores stowing away, even best practices can't eradicate the problem. According to current guidelines, there should be no more than 300 spores per square meter on spacecraft bound for Mars.

We expect that anything that has evolved for billions of years in a terrestrial environment would be unlikely to survive a trip through space on the outside of a rocket. But any species robust enough to survive decontamination within a spacecraft may also be among the most capable of enduring the journey through space.
Most of the research in that direction has focused on bacteria, which produce spores that act as a sort of life raft or survival capsule when conditions become harsh. By contrast, less attention has been paid to fungi in planetary protection research, some of which have demonstrated resilience under extreme conditions.
According to Article IX of the UN's Outer Space Treaty of 1967, any space exploration must take steps to avoid the harmful contamination of other worlds. This means that we need to know what potential contaminants could feasibly hitch a ride across the Solar System and set up shop on another planet or moon.
Venkateswaran and his colleagues swabbed NASA cleanrooms used in the Mars 2020 program to obtain a better grasp of the potential fungal threat. Specifically, they wanted to identify fungal spores, called conidia, to see whether any could survive the simulated conditions of space travel.
Even the decontaminated cleanrooms yielded 27 fungal strains.
Next, the researchers cultured these fungi and harvested their conidia, and subjected them to a battery of tests.
These included intense ultraviolet irradiation, much stronger than anything they would naturally experience on Earth; extremely low pressure, consistent with Mars conditions; extreme cold down to -60 degrees Celsius (-76 Fahrenheit), similar to low temperatures on Mars; Mars-like dust; and radiation exposure similar to the cosmic radiation dose of a trip to Mars.
Of the 27 initial strains, 23 survived the UV irradiation. However, one species, A. calidoustus, was the standout survivor. Its conidia managed to survive UV radiation, months of space-like ionizing radiation exposure, and the Mars-like atmospheric conditions.
The only thing that could reliably kill the fungus was prolonged exposure to a combination of Mars-like high radiation and extreme cold.
"The capacity for fungal conidia to survive multiple space-relevant conditions suggests their potential as forward contaminants, capable of being transported to and persisting on Mars," the researchers write in their paper.
The results don't mean we need to panic immediately about fungal spores seeding Mars. But they do suggest that fungi represent a critical, overlooked gap in current interplanetary contamination strategies, especially as humanity stands poised on the brink of a new era of space exploration with the Artemis program.
Related: Chernobyl Fungus Seems to Have Evolved an Incredible Ability
Aspergillus species are also associated with health complications, particularly respiratory conditions such as aspergillosis. This means finding ways to minimize their presence on spacecraft could help ensure astronaut health and safety on long missions.
"Together, these investigations help refine NASA's planetary protection strategies and microbial risk assessment approaches for current and future space exploration missions," Venkateswaran says.
The research has been published in Applied and Environmental Microbiology.